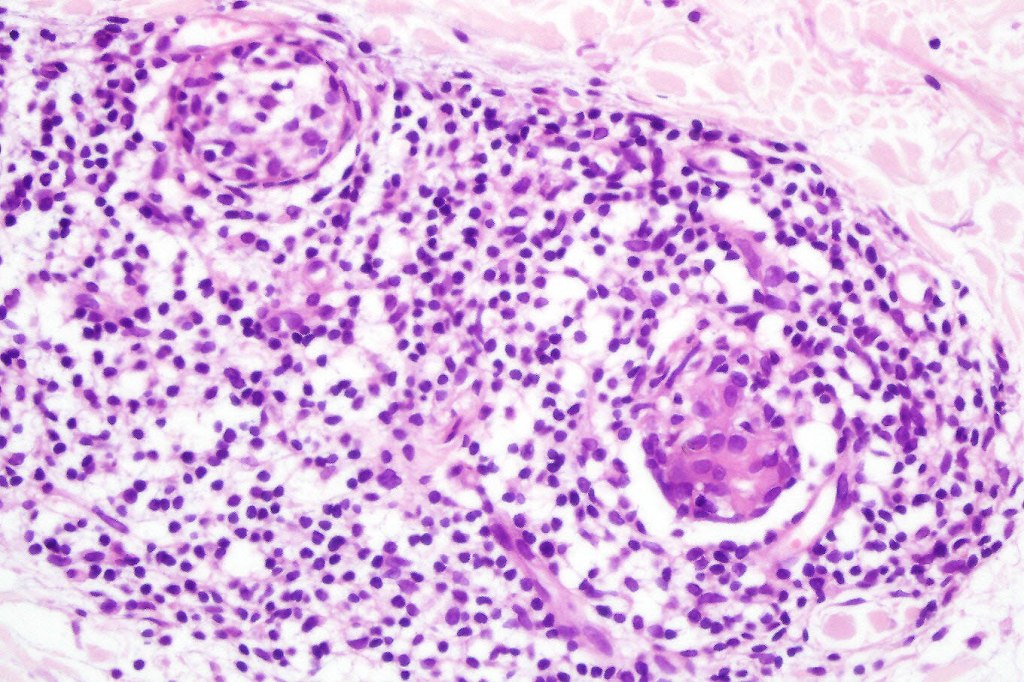
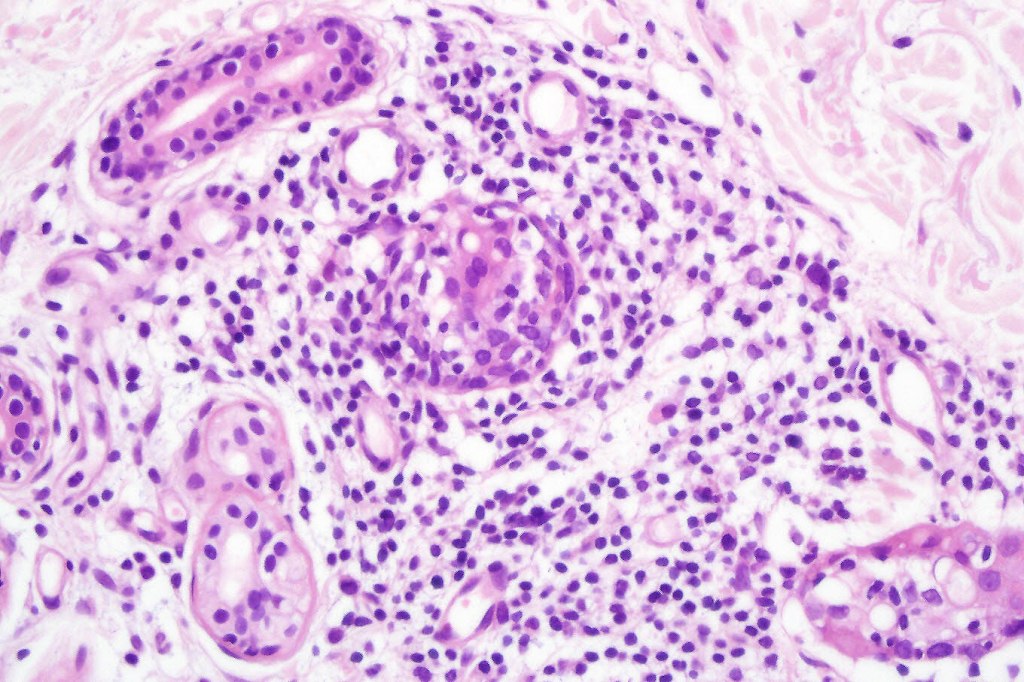
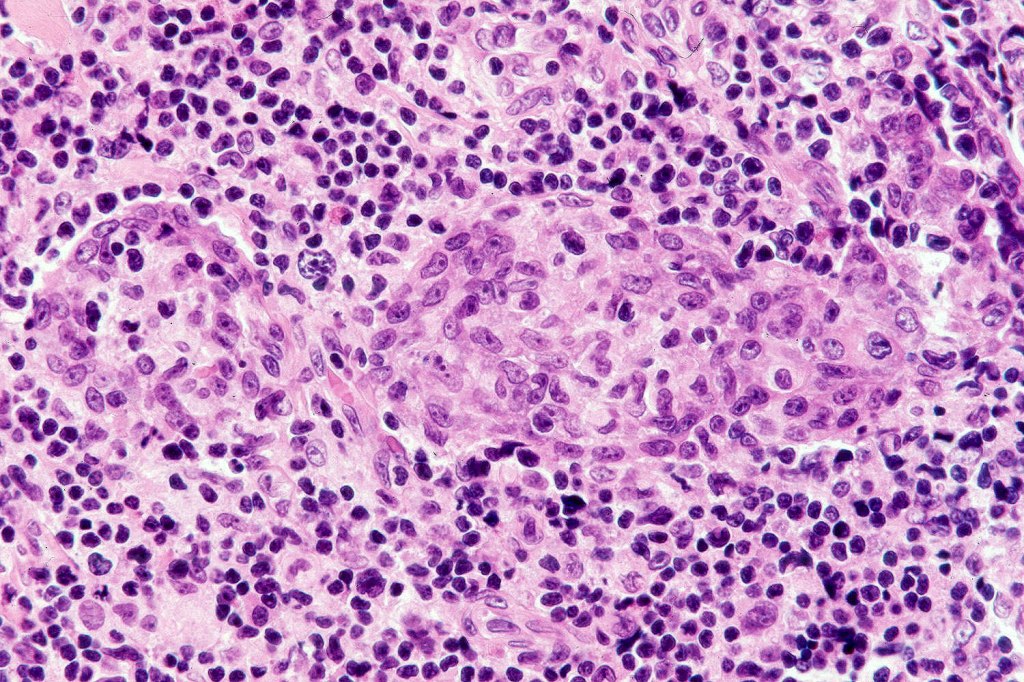
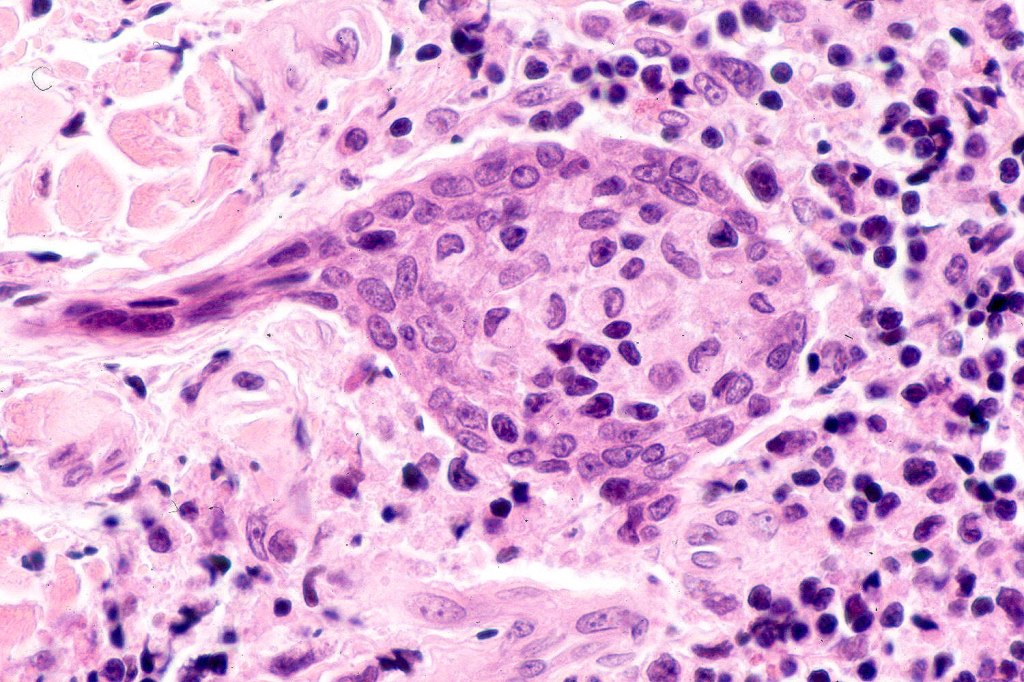

Clinical features
•Often but not always accompanies folliculotropic mycosis fungoides
•M>F
•Wide age range (33-83, mean 58 years)
•Presents as small papules in patch or plaque stage disease, variable hair loss
•Limbs are most affected and to a lesser extent, the head & neck & trunk

Histology may show epidermal involvement and folliculotropism. The characteristic feature is the presence of a heavy deep dermal atypical lymphocytic infiltrate surrouding and infiltrating the sweat gland & ductal epithelium. Variable numbers of Sézary cells may be present.

Leave a comment